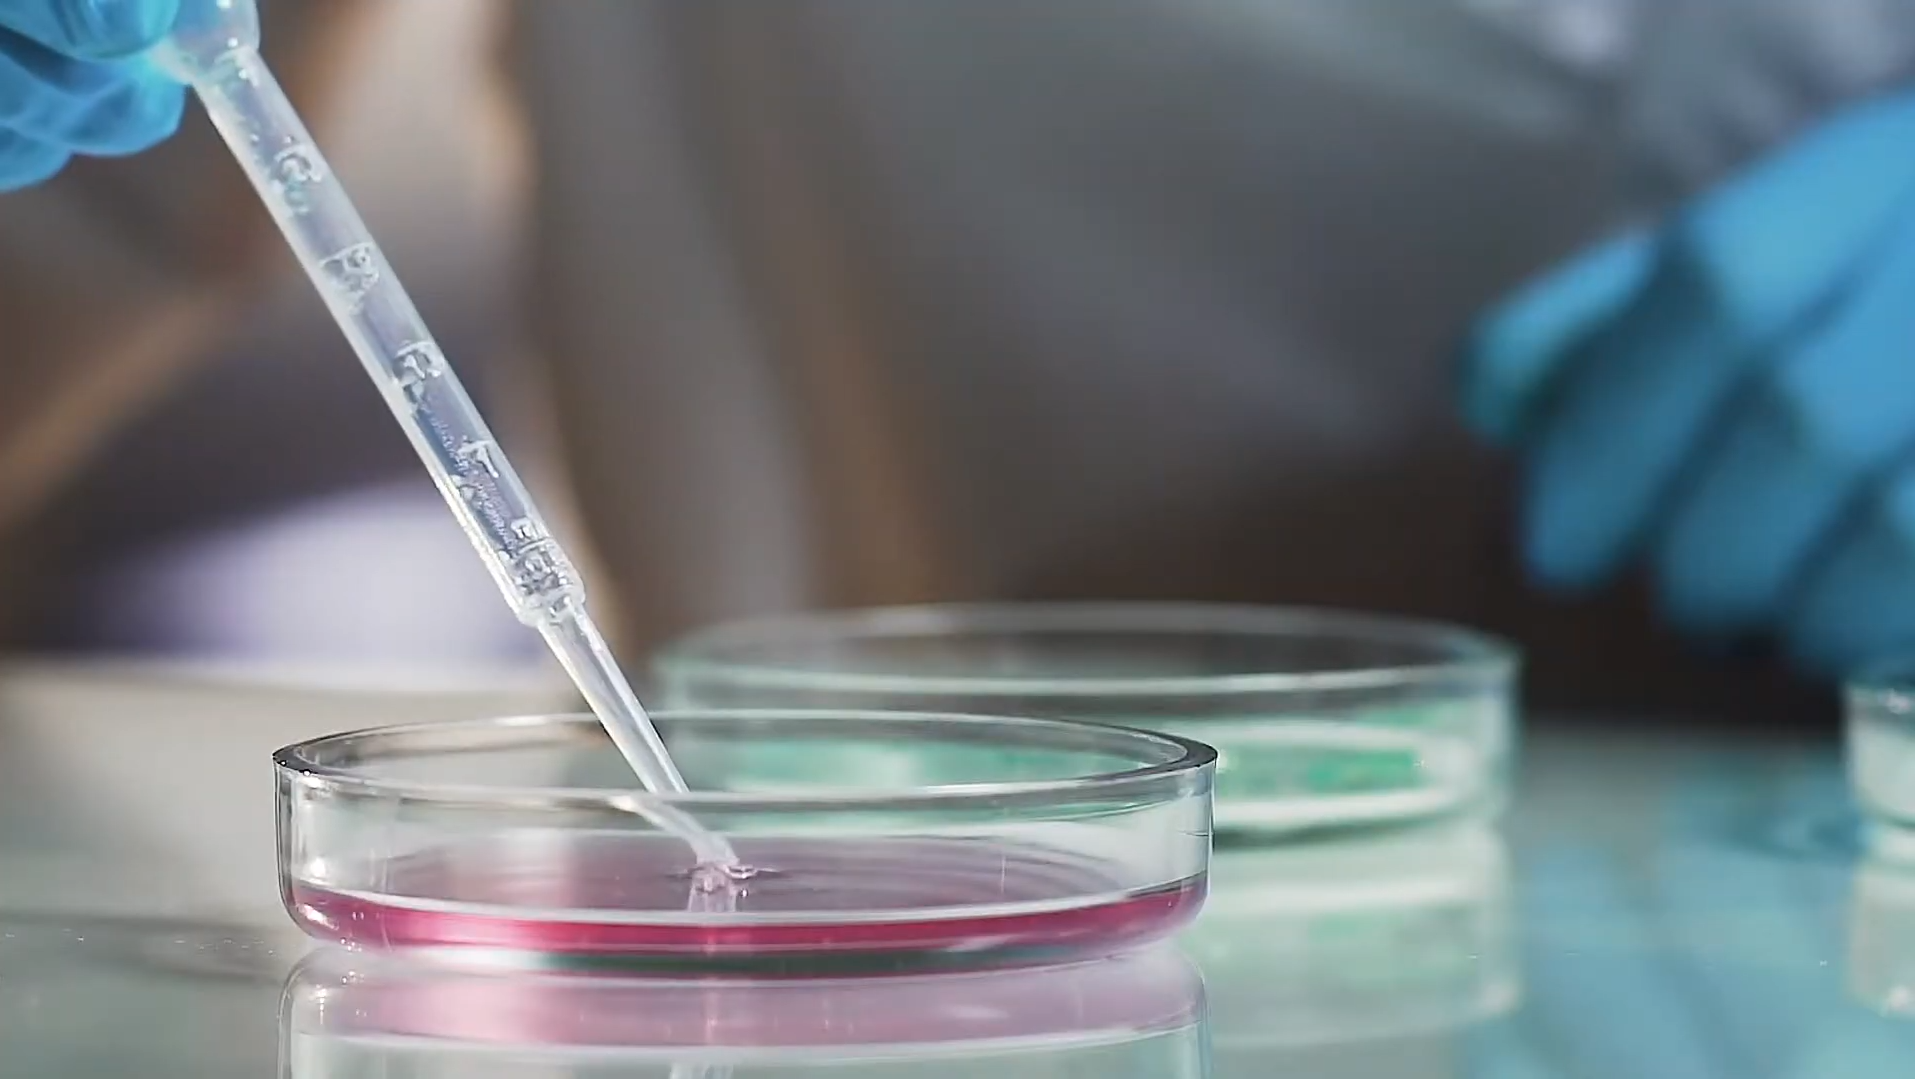
Pesquisa e Desenvolvimento

Excelência em Fabricação
Com mais de 30 anos de experiência, a Lipson é referência na fabricação de cosméticos para terceiros. Nosso compromisso é desenvolver produtos de alta qualidade, unindo tecnologia avançada a matérias-primas cuidadosamente selecionadas, sempre com o objetivo de superar as expectativas de nossos clientes. Contamos com uma equipe especializada em pesquisa e desenvolvimento, garantindo inovação constante e um portfólio atualizado, alinhado às tendências do mercado de cosméticos.


Soluções de alto padrão em todo o desenvolvimento do projeto

Body Care

Make Up

Skin Care

Amostragens

Sun Care

Fragrâncias

Hair Care

Rua Inco, 210 - Diadema - SP - Brasil - CEP: 09961-370